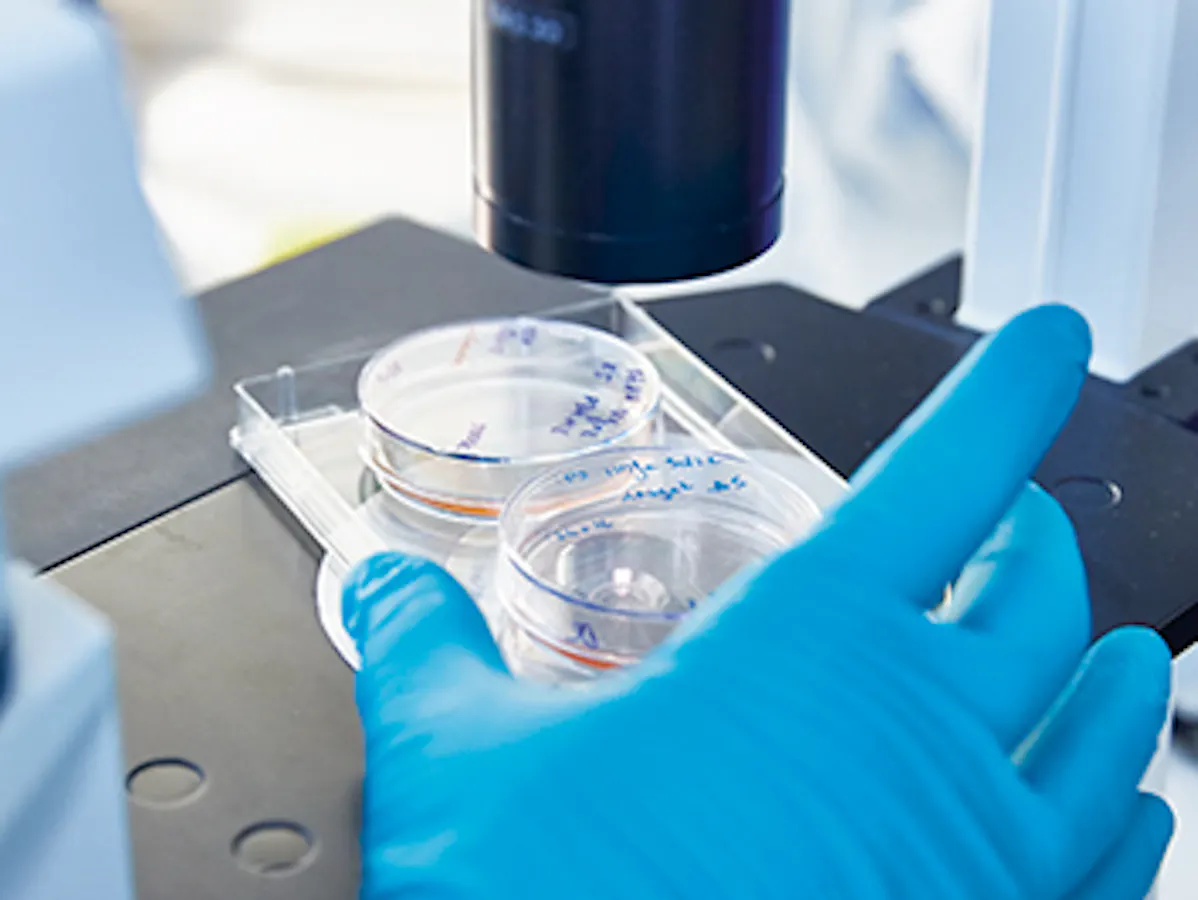
content-image

Dieser Artikel wurde ursprünglich im August 2015 publiziert.
Publiziert am 30/06/2020
Ein Wunder der Natur: Eine winzige, befruchtete Eizelle trägt das Potenzial in sich, aus sich heraus einen ganzen Menschen zu bilden – eine Fähigkeit, die Wissenschaftler als Totipotenz bezeichnen. Schon nach drei Zellteilungen haben sich die Tochterzellen jedoch so weit differenziert, dass sie diese Fähigkeit verloren haben.
Doch diese embryonalen Stammzellen können immer noch sehr viel, nämlich zu jedem beliebigen Zelltyp im menschlichen Körper heranreifen. Deshalb nennt man sie auch pluripotent. Erst die fertigen Muskel-, Nerven- oder Blutzellen sind so spezifisch ihren Aufgaben angepasst, dass sie diese Fähigkeit verloren haben.
Die Entwicklung unserer Zellen ist also eine Einbahnstrasse – zumindest im lebenden Organismus. Für Zellen im Labor wurde dieses Prinzip jedoch ausser Kraft gesetzt. Dieser Durchbruch, der zahlreichen Therapien Tür und Tor öffnete, ist hauptsächlich zwei Forschern zu verdanken: den beiden Nobelpreisträgern John B. Gurdon und Shinya Yamanaka.